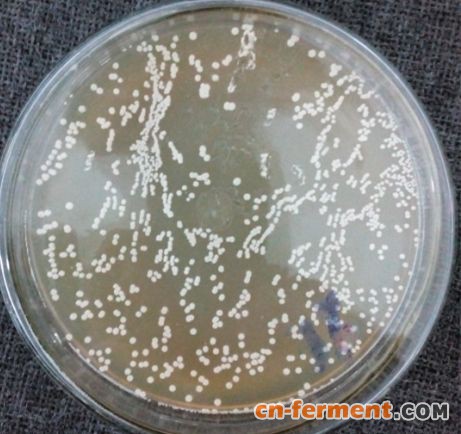

技术转让
200万转让丙酮酸高产菌种和发酵技术(已完成中试)
2019-09-02 17:315977
信息概况
-
价格:未填
联系方式
同类行业服务
各地最新发酵项目
-
发酵项目9个月前
-
发酵项目2年前
-
发酵项目3年前
-
发酵项目6年前
-
发酵项目4年前
-
发酵项目4年前
-
发酵项目4年前
-
发酵项目11年前
-
发酵项目4年前
- 查看更多
可租售发酵工厂
-
制药厂2个月前
-
发酵工厂招商11个月前
- 查看更多
寻租赁代加工服务需求
-
求购技术2天前
-
求购技术2天前
-
求购技术1星期前
-
求购技术1星期前
-
求购技术16年前
-
求购技术1星期前
-
求购技术1星期前
-
求购技术1个月前
- 查看更多